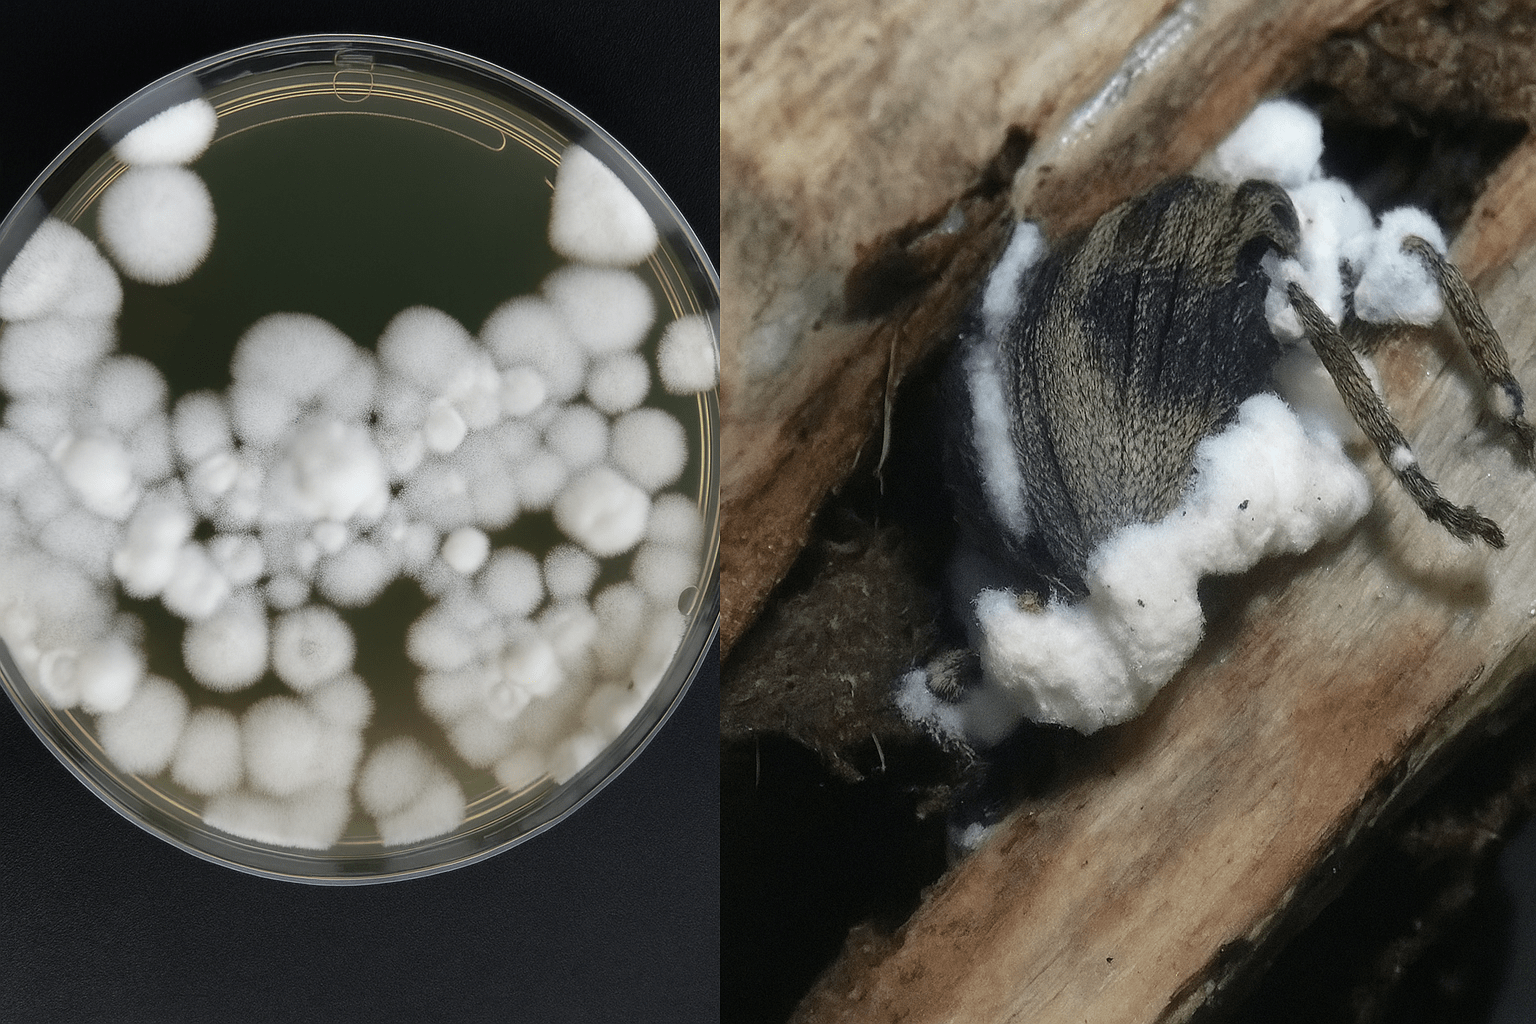

O biocontrole vem ganhando protagonismo como solução no manejo de doenças em plantas. Nas imagens acima, colônias do fungo Beauveria bassiana e inseto da broca da haste da mandioca infectado pelo fungo (Fotos: Adilson Lima/Embrapa Amapá)
Uso de organismos vivos para proteger as plantas e reduzir a dependência de produtos químicos avança em ritmo acelerado no Brasil, impulsionado por inovação científica, políticas públicas e pela crescente demanda por alimentos produzidos de forma mais sustentável.
De acordo com a consultoria Research and Markets, o mercado global de produtos de biocontrole movimentou US$ 8,2 bilhões em 2023 e deve atingir US$ 25,7 bilhões até 2030. O Brasil lidera esse crescimento.
Dados da empresa Kynitec mostram que a área potencial tratada com agentes de biocontrole passou de 35 milhões de hectares na safra 2021/2022 para 58 milhões em 2023/2024 — uma alta de mais de 29% em cinco anos.
Os bionematicidas são os que mais crescem, respondendo por 47% da área tratada, à frente dos bioinseticidas (36%) e biofungicidas (17%). Em culturas como soja, milho e algodão, o uso de bionematicidas já supera o de produtos químicos.
Em 2015, eles representavam apenas 6% do mercado nacional; em 2022, chegaram a 75%, enquanto os nematicidas químicos caíram de 94% para 25%. Apesar do avanço, os bioprotetores ainda representam apenas 4% do total de produtos fitossanitários utilizados no Brasil, o que indica amplo potencial de expansão.
Entre os agentes mais utilizados estão os fungos Trichoderma spp., Beauveria bassiana, Metarhizium anisopliae, Isaria fumosorosea e Clonostachys rosea, além das bactérias Bacillus subtilis, B. amyloliquefaciens, B. licheniformis, B. methylotrophicus, B. velezensis e B. thuringiensis.
Esses microrganismos combatem patógenos do solo e da parte aérea das plantas por diferentes mecanismos. Trichoderma, por exemplo, age por parasitismo, competição, antibiose e estímulo à defesa da planta. Já as espécies de Bacillus se destacam pela capacidade de formar biofilmes, produzir metabólitos antimicrobianos e induzir resistência sistêmica.
No país, Trichoderma responde por cerca de 17% da área tratada com bioprotetores, Beauveria, por 16%, e as espécies de Bacillus cobrem aproximadamente 25% da área protegida.
O que são bioprotetores
Os bioprotetores vêm ganhando protagonismo como solução estratégica no manejo de doenças em plantas. Mais do que substituir agroquímicos, esses produtos baseados em organismos vivos — como fungos, bactérias, vírus e até ácaros — atuam de forma inteligente, protegendo as culturas agrícolas sem agredir o meio ambiente, a saúde dos agricultores e dos consumidores.
Diferentemente dos chamados “fungicidas ou biofungicidas”, que pressupõem a morte do patógeno, os bioprotetores atuam por outros mecanismos, como competição, parasitismo, antibiose e indução de resistência da planta.
Por isso, o termo bioprotetor tem sido cada vez mais adotado por especialistas, por englobar as diversas formas de ação desses organismos. Em vez de eliminar o agente causador da doença, muitos bioprotetores fortalecem as defesas naturais das plantas, competem por nutrientes e espaço e estabilizam o ambiente, prevenindo novos surtos.
O controle biológico é definido como a redução da atividade de agentes causadores de doenças por meio da ação de organismos vivos, excluindo-se a intervenção direta do homem. Ele pode ocorrer de forma natural, conservacionista, clássica (introdução de inimigos naturais) ou aumentativa (aplicação em larga escala).
Além de microrganismos, os bioprotetores podem incluir plantas geneticamente melhoradas, organismos antagonistas e produtos naturais derivados desses seres vivos. Eles são frequentemente integrados a práticas culturais sustentáveis, criando ambientes mais favoráveis às plantas e menos propícios às doenças.
Novos agentes e tecnologias
Pesquisadores vêm ampliando as fronteiras do biocontrole ao explorar agentes não tradicionais, como micovírus — vírus que infectam fungos e reduzem sua virulência, já usados na China contra o crestamento do castanheiro — e bacteriófagos, vírus que atacam bactérias específicas sem afetar humanos ou animais, com potencial de uso contra doenças bacterianas em plantas.
Outros exemplos são os ácaros predadores e micófagos, como Orthotydeus lambi e Ricoseius loxocheles, que ajudam a controlar o oídio da videira e a ferrugem do cafeeiro, respectivamente.
O desafio, porém, está em viabilizar a produção em larga escala desses organismos e desenvolver formulações compatíveis com defensivos agrícolas.
O processo de desenvolvimento de um bioprotetor é rigoroso e inclui desde o isolamento de microrganismos antagonistas no ambiente até testes de campo, formulação estável e integração ao sistema produtivo.
Casos como o controle do mofo-branco da soja com Trichoderma e Bacillus mostram como o sucesso depende da integração do bioprotetor ao manejo agrícola, inclusive nas culturas subsequentes.
LEIA TAMBÉM:
Prevenção e defesa natural da planta são fundamentais para produtividade de soja e milho
Produto natural promete impulsionar cadeia da tilápia
Técnicas simples reduzem o “mato” e dispensam herbicidas em lavouras orgânicas
Políticas públicas e inovação
O avanço do uso de bioprotetores no país também reflete o impacto do Programa Bioinsumos, criado em 2020 pelo Ministério da Agricultura e Pecuária (Mapa). A iniciativa promove o desenvolvimento de produtos e tecnologias biológicas que melhorem a saúde do solo, estimulem o crescimento das plantas e tornem os sistemas agropecuários mais sustentáveis.
Segundo o decreto que instituiu o programa, bioinsumos são produtos ou tecnologias de origem vegetal, animal ou microbiana que interferem positivamente no crescimento e na defesa das plantas e podem ser usados em todas as etapas da produção de alimentos.
Para o pesquisador da Embrapa Meio Ambiente Wagner Bettiol, ainda há desafios a superar:
“É preciso desenvolver bioherbicidas para reduzir o uso de químicos no controle de plantas daninhas, ampliar a diversidade de microrganismos disponíveis comercialmente, produzir fungos em sistemas mais sustentáveis, desenvolver produtos adaptados às mudanças climáticas e que aumentem a eficiência do uso de nutrientes, abrir coleções microbianas públicas e investir em formação técnica e científica de profissionais da cadeia dos bioinsumos”.
Ele acrescenta que a substituição de agroquímicos por bioprotetores não é apenas uma tendência de mercado, é uma resposta à demanda por práticas agrícolas mais conscientes, seguras e resilientes, protegendo as plantas sem comprometer o meio ambiente e a saúde dos trabalhadores rurais.
Bettiol conclui dizendo que o “ Brasil tem tudo para seguir como líder mundial no desenvolvimento e uso de bioprotetores”.